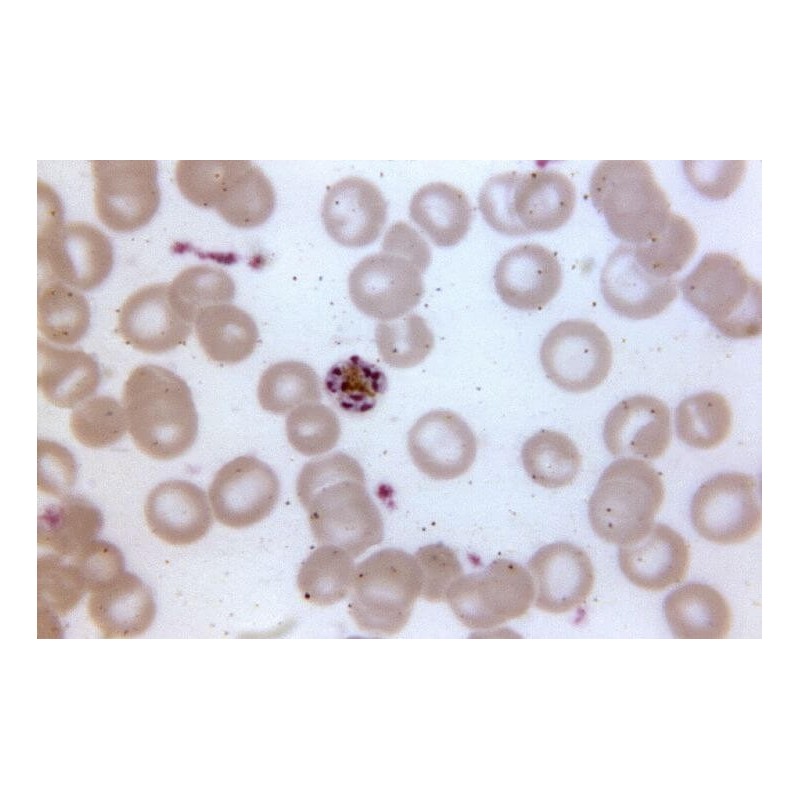
Краситель Райта, 100гр

Краситель эозин-метиленовый синий по Райту для дифференциации форменных элементов крови, бактериологии (выделение спирохет и простейших), цитогенетики.
Краситель эозин-метиленовый синий по Райту для дифференциации форменных элементов крови, бактериологии (выделение спирохет и простейших), цитогенетики.
Представляет собой модификацию классической смеси эозина и метиленовой сини по Романовскому. Применяют для дифференцирующего окрашивания в основном периферических мазков крови (выделение белых клеток крови) и цитологических препаратов (аспиратов костного мозга), которые исследуют под световым микроскопом. В цитогенетике им окрашивают хромосомы, чтобы облегчить диагностику синдромов и заболеваний. А также для выявления некоторых простейших (Giardia lamblia, Entamoeba histolitica, Plasmodium spp.) и микроорганизмов (Microfilaria, Babesia, Haemobartonella, Pneumocystis, Helicobacter, Treponema pallidum, Borrelia spp.)
Не удаётся отправить вашу оценку отзыва
Пожаловаться на комментарий
Жалоба отправлена
Не удаётся отправить вашу жалобу
Оставьте свой отзыв
Отзыв отправлен
Не удаётся отправить отзыв
Краситель эозин-метиленовый синий по Райту для дифференциации форменных элементов крови, бактериологии (выделение спирохет и простейших), цитогенетики.
check_circle
check_circle
















